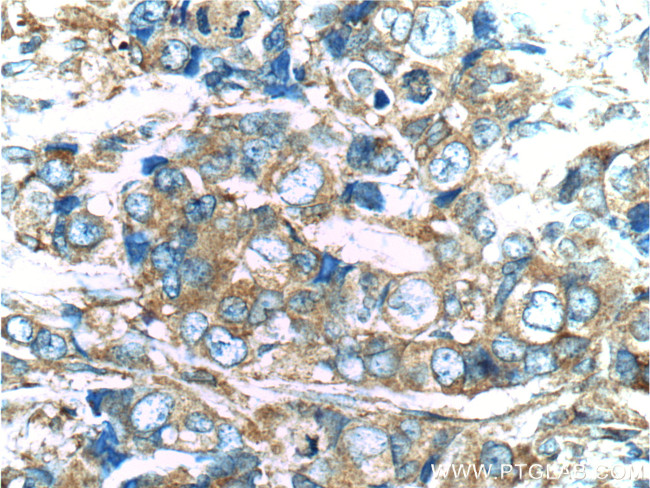
PKC zeta Antibody in Immunohistochemistry (Paraffin) (IHC (P))

Search
Proteintech
PKC zeta Polyclonal Antibody
{{$productOrderCtrl.translations['antibody.pdp.commerceCard.promotion.promotions']}}
{{$productOrderCtrl.translations['antibody.pdp.commerceCard.promotion.viewpromo']}}
{{$productOrderCtrl.translations['antibody.pdp.commerceCard.promotion.promocode']}}: {{promo.promoCode}} {{promo.promoTitle}} {{promo.promoDescription}}. {{$productOrderCtrl.translations['antibody.pdp.commerceCard.promotion.learnmore']}}
产品信息
10860-1-AP
种属反应
已发表种属
宿主/亚型
分类
类型
抗原
偶联物
形式
浓度
规格
纯化类型
保存液
内含物
保存条件
运输条件
产品详细信息
Immunogen sequence: SQGLGLQDF DLIRVIGRGS YAKVLLVRLK KNDQIYAMKV VKKELVHDDE DIDWVQTEKH VFEQASSNPF LVGLHSCFQT TSRLFLVIEY VNGGDLMFHM QRQRKLPEEH ARFYAAEICI ALNFLHERGI IYRDLKLDNV LLDADGHIKL TDYGMCKEGL GPGDTTSTFC GTPNYIAPEI LRGEEYGFSV DWWALGVLMF EMMAGRSPFD IITDNPDMNT EDYLFQVILE KPIRIPRFLS VKASHVLKGF LNKDPKERLG CRPQTGFSDI KSHAFFRSID WDLLEKKQAL PPFQPQITDD YGLDNFDTQF TSEPVQLTPD DEDAIKRIDQ SEFEGFEYIN PLLLSTEESV (244-592 aa encoded by BC014270)
靶标信息
The PKC family of serine/threonine kinases, including PRKCZ (PKC zeta), is activated intracellularly by signal transduction pathways. In humans, at least 12 different PKC polypeptides have been identified. These isoforms differ in primary structure, tissue distribution, subcellular localization, mode of action in vitro, response to extracellular signals, and substrate specificity. PKC alpha, beta I, beta II and gamma form the conventional family; their activities are Ca2+- and phospholipid-dependent. PKC zeta plays a key regulatory role in a variety of cellular functions including cell growth and differentiation, gene expression, hormone secretion and membrane function.
仅用于科研。不用于诊断过程。未经明确授权不得转售。
生物信息学
蛋白别名: atypical protein kinase C; kinase nPKC-zeta; KPCZ; nPKC-zeta; nPKC-zeta PRKCZ; protein kinase C zeta subspecies; Protein kinase C zeta type; unnamed protein product
基因别名: AI098070; aPKCzeta; C80388; nPKC-zeta; PKC-ZETA; PKC2; Pkcz; PRKCZ; R74924; zetaPKC
UniProt ID: (Human) Q05513, (Mouse) Q02956
Entrez Gene ID: (Human) 5590, (Mouse) 18762